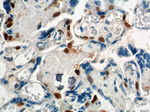
p57Kip2 Antibody in Immunohistochemistry (Paraffin) (IHC (P))

Search
Proteintech
p57Kip2 Polyclonal Antibody
{{$productOrderCtrl.translations['antibody.pdp.commerceCard.promotion.promotions']}}
{{$productOrderCtrl.translations['antibody.pdp.commerceCard.promotion.viewpromo']}}
{{$productOrderCtrl.translations['antibody.pdp.commerceCard.promotion.promocode']}}: {{promo.promoCode}} {{promo.promoTitle}} {{promo.promoDescription}}. {{$productOrderCtrl.translations['antibody.pdp.commerceCard.promotion.learnmore']}}
产品信息
23317-1-AP
种属反应
已发表种属
宿主/亚型
分类
类型
抗原
偶联物
形式
浓度
规格
纯化类型
保存液
内含物
保存条件
运输条件
产品详细信息
Immunogen sequence: MSDASLRST STMERLVARG TFPVLVRTSA CRSLFGPVDH EELSRELQAR LAELNAEDQN RWDYDFQQDM PLRGPGRLQW TEVDSDSVPA FYRETVQVGR CRLLLAPRPV AVAVAVSPPL EPAAESLDGL EEAPEQLPSV PVPAPASTPP PVPVLAPAPA PAPAPVAAPV AAPVAVAVLA PAPAPAPAPA PAPAPVAAPA PAPAPAPAPA PAPAPAPDAA PQESAEQGAN QGQRGQEPLA DQLHSGISGR PAAGTAAASA NGAAIKKLSG PLISDFFAKR KRSAPEKSSG DVPAPCPSPS AAPGVGSVEQ TPRKRLR (1-316 aa encoded by BC067842)
靶标信息
This gene is part of a gene cluster on chromosome Xp11.23. The encoded protein contains a zinc finger motif often found in transcriptional regulators, however, its exact function is not known. Alternative splicing results in multiple transcript variants encoding the same protein.
仅用于科研。不用于诊断过程。未经明确授权不得转售。
生物信息学
蛋白别名: Beckwith Wiedemann syndrome (WBS); Cyclin dependent kinase inhibitor 1C (CDKN1C); Cyclin-dependent kinase inhibitor 1C; cyclin-dependent kinase inhibitor 1C (p57, Kip2); Cyclin-dependent kinase inhibitor p57; IMAGE; p57 Kip2; p57Kip2
基因别名: BWCR; BWS; CDKN1C; KIP2; p57; p57Kip2; WBS
UniProt ID: (Human) P49918
Entrez Gene ID: (Human) 1028